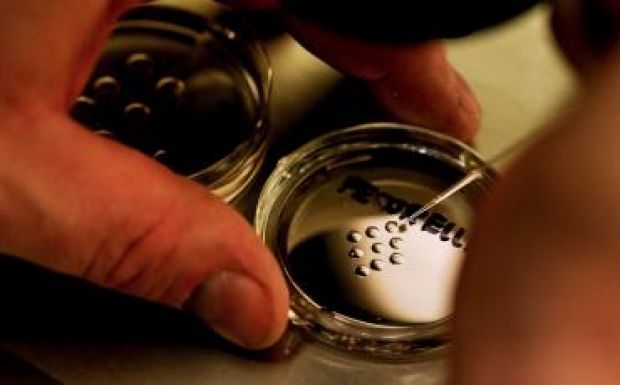

Genetikailag módosított szúnyogokkal szabadulnának a szúnyogoktól a horvátok
A következő két hét során százezer genetikailag módosított szúnyogot engednek szabadon Zágrábban, hogy elpusztítsák a természetes állományt - írta az Index.hr internetes portál csütörtökön.
A horvát fővárosban a legnagyobb számban az ázsiai tigrisszúnyog vagy napszúnyog, latin nevén Aedes albopictus telepedett meg.
Az úgynevezett steril rovartechnika módszerével Európában az elmúlt években több kutatást és kísérletet végeztek a tigrisszúnyogok számának csökkentésére, így Olaszországban, Portugáliában, Spanyolországban, Görögországban és Szerbiában. Tavaly már az isztriai Pulában is alkalmazták az eljárást.
Genetikailag módosított steril hímeket engednek el, amelyek a természetben élő nőstény szúnyogokkal fognak párosodni. Ennek eredményeként a nőstények olyan petéket hoznak létre és raknak le, amelyekből nem fejlődnek ki újabb szúnyogegyedek - magyarázta a portálnak Ana Klobucar, a közegészségügyi intézet munkatársa. Kiemelte: a laboratóriumban tenyésztett steril hím tigrisszúnyogokat körülhatárolt területen engedik szabadon. Később befogják őket, hogy meghatározzák, milyen messzire repültek el az adott helytől, valamint túlélési képességüket városi körülmények között. Több tojáscsapdát is felállítottak, hogy megvizsgálhassák a lerakott lárvákat.
Klobucar elmondta, hogy a projektet Zágráb városa finanszírozza, és körülbelül 10 ezer euróba kerül. A génmódosított szúnyogok Olaszországból származnak, a projekttől pedig azt várják, hogy jelentősen csökkenti a tigrisszúnyogok számát.
A tigrisszúnyognak nemcsak a csípése fájdalmas, de azon fajok közé tartozik, amelyek képesek betegségek terjesztésére is.

.jpg)

.jpg)


_(1).jpg)





.jpg)



